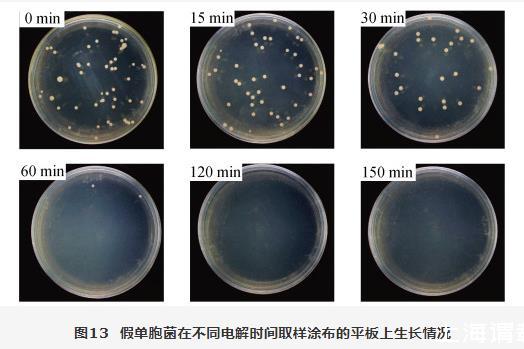

熱線:021-66110810,66110819
手機:13564362870


熱線:021-66110810,66110819
手機:13564362870
2、結果與討論
2.1氧化炭黑的結構表征
氧化前后炭黑的形貌通過SEM和TEM表征,通過結果可以看出樣品整體呈現典型的不規則的球形顆粒形貌。對比觀察氧化處理前后的炭黑樣品,發現氧化處理后,催化材料原有形貌沒有改變(圖3)。
XRD結果表明O?CB與CB均在25°和40°有明顯的衍射峰,分別對應石墨碳的(002)和(100)晶面。通過XRD譜上(002)峰的強度可以反映碳材料的石墨化程度,一般而言石墨化程度越高,碳材料的導電性和化學穩定性越好。因此,氧化處理不會破壞炭黑的結構,同時,保留了炭黑的高石墨化度的特點(圖4)。

圖3氧化前后炭黑材料的形貌圖

圖4 CB和O?CB的X射線衍射圖
此外,我們通過氮氣吸脫附實驗表征材料內部的孔結構和材料的比表面積。一般而言,催化劑的比表面積越高,可以承載更多的催化活性位點,因而具有更高的電催化活性。結果表明O?CB樣品的平均孔徑為95.611?,為介孔結構,且樣品在0.8~1.0范圍內出現回滯環(圖5),且與CB的比表面積(115.500 4 m2/g)相比,處理后的O?CB(342.876 8 m2/g)具有更高的比表面積,這表明通過化學氧化處理不僅保持材料原有結構和形貌不變,而且能夠增加O?CB的比表面積,使其具有更高的催化活性。
羧基,羰基,醚鍵等含氧官能團,被認為是氧摻雜碳材料的氧還原反應產生H2O2催化活性來源。通過XPS表征可以獲得表面元素的種類和價態信息。XPS結果表明,C 1s可以分為C=C鍵(284.8 eV),C?C鍵(285.5 eV),C?O鍵(286.8 eV),O=C?O鍵(289.0 eV)(圖6a)。O 1s可以擬合為531.8 eV、532.9 eV、534 eV、536 eV 4個峰,分別對應C=O鍵,C?O?C或COOH鍵,C?OH鍵,化學吸附氧(圖6b)。以上結果證明,通過硝酸氧化處理后,獲得的O?CB表面引入了多種氧官能團,其中的C?O?C鍵或?COOH含量最高。

圖5 O?CB催化劑的氮氣吸脫附曲線
2.2氧化炭黑電催化性能評價
為了評價O?CB的電催化性能,RRDE技術被用于測定O?CB在中性的氯化鈉溶液(pH≈7)中的電催化性能。首先,通過對比氮氣飽和溶液條件和氧氣飽和溶液條件下的CV曲線,結果發現O?CB對氧還原反應(ORR)具有明顯的電催化活性(圖7)。
利用旋轉環盤電極技術測得O?CB在1 600 r/min轉速下的極化曲線,通過計算公式得出該催化材料的轉移電子數為2.7,H2O2選擇性約為60%(圖8)。上述電化學實驗結果證明所制備的O?CB催化劑具有較高的催化活性和H2O2選擇性,在中性氯化鈉溶液中能夠電催化氧還原反應產生H2O2。

圖6 O?CB催化劑的XPS精細譜圖

圖7 O?CB催化劑在0.5 mol·L–1的氯化鈉溶液中的CV曲線圖

圖8基于RRDE獲取的極化曲線所計算的H2O2選擇性和轉移電子數結果
2.3 O?CB/PTFE電極的電催化性能分析
通過SEM觀察,碳氈基底呈現光滑的碳纖維交織組成的多孔網狀結構,通過噴涂-熱解過程,將O?CB催化劑包覆到碳纖維的表面而使其表面呈現疏松多孔的形貌,對單根纖維表面進行放大觀察尤為明顯(圖9)。此外,當噴涂PTFE比重為20 wt%時,在碳纖維表面出現團聚現象,這是由于過多的PTFE會導致結塊(圖9d),這種團聚的催化劑可能會影響實際的電催化性能。
此外,為了評估PTFE對電極表面浸潤性及氣體界面調控的影響,我們測試電極表面的固-液接觸角,結果表明不同PTFE修飾量的電極表面的接觸角均大于130°,呈現為疏水化表面。這證明了PTFE有助于電極表面疏水界面層的形成,然而改變用量對電極表面的疏水性的影響差別并不明顯(圖10)。
基于硫酸鈰比色法原理,結合紫外可見吸收光譜,經過進一步計算得到H2O2的電催化產生速率(圖11)。對比不同含量PTFE修飾的電極在0.1 V、0.2 V、0.3 V vs RHE電位下的H2O2產生速率,可以發現在不同電位下,噴涂PTFE比重為20 wt%的均明顯低于其他用量。且5 wt%對應的電極產率最高,在0.1 V vs RHE電位下可以達到27.19 mg·L?1(mgcatalyst)?1·cm?1·h?1,10 wt%的電極次之。證明PTFE的用量確實會影響電極實際電催化產生的H2O2的量,與SEM觀察到的結果相符。這可能是由于PTFE用量過多導致產量明顯降低。另外,PTFE本身不導電且沒有電催化活性,過多的添加會阻礙電子傳遞,降低催化位點的暴露,從而降低實際的電催化產生H2O2的效果;其次,使用過少的PTFE修飾,導致電極表面的疏水界面層不穩定,從而不利于形成氧氣擴散傳質的固-液-氣三相界面層,進而限制了整個電催化過程的發生。因此,適量的PTFE修飾不僅有利于電子傳遞,而且利于氧氣擴散,通過優化PTFE的用量,可以提高電催化產生H2O2的實際產量。當PTFE添加量為5 wt%時,對氧氣擴散和電子阻礙作用達到一個相對平衡的狀態,此時實現相對更大的H2O2產量。

圖9不同PTFE修飾量的O–CB/PTFE電極的掃描電鏡圖
注:(a)PTFE-2.5 wt%;(b)PTFE-5 wt%;(c)PTFE-10 wt%;(d)PTFE-20 wt%

圖10不同PTFE修飾量的O?CB/PTFE電極表面的接觸角
注:(a)PTFE-2.5 wt%;(b)PTFE-5 wt%;(c)PTFE-10 wt%;(d)PTFE-20 wt%

圖11不同PTFE修飾量的O?CB/PTFE電極在相應電位下的H2O2產生速率
2.4殺菌效果分析
為了測試O?CB/PTFE-5 wt%電極實際的電催化殺菌消毒效果,我們選擇sp作為模式菌進行相關實驗。為防止電解液成分對細菌存活狀態的影響,我們選擇在中性pH的PBS電解液中進行測試。根據平板計數結果,計算得到相應電催化過程的殺菌率曲線,誤差棒代表3個平行培養平板間誤差(圖12)。從結果來看,O?CB/PTFE-5 wt%電極在電催化30 min內可以殺滅48.5%的細菌,60 min內即可滅殺97.69%的細菌,對sp.實現較強的抗菌作用,120 min內可殺滅99.99%以上的細菌。

圖12殺菌率隨處理時間的關系曲線
相同稀釋倍數涂布的平板,經過過夜培養后,通過對比平板上細菌的菌落結果,可以直觀地看出由于活性氧逐漸積累,細菌隨著處理時間增加而被徹底殺滅。當處理時間為60 min時,細菌幾乎不生長。持續作用120 min,平板上沒有細菌菌落生長。因此,O?CB/PTFE-5 wt%電極用于電催化產生的H2O2等活性氧物質作用于sp,在短時間內就呈現出很好的殺菌效果(圖13)。
圖13假單胞菌在不同電解時間取樣涂布的平板上生長情況
3、結論
本文利用炭黑為原料,通過化學氧化的方法在炭黑表面引入豐富含氧官能團并利用噴涂-熱解工藝成功制備O?CB/PTFE電極。該電極在中性氯化鈉介質中高效電催化產H2O2。研究結果表明,適量的PTFE修飾可以有利于電極表面氧氣擴散,進而提高H2O2產生速率;O-CB/PTFE-5 wt%電極最高可以達到27.19 mg·L–1·(mgcatalyst)–1·cm–1·h–1產生速率。以sp為海洋污損微生物的模式菌,進一步評價O?CB/PTFE-5 wt%電極電催化產生活性氧的殺菌效果。殺菌實驗證明利用該電極可以電催化持續不斷產生活性氧,在60 min內即可滅殺97.69%的細菌,對sp.實現較強的抗菌作用,在120 min內,對假單胞菌可達到99.99%的殺菌率。O?CB/PTFE電極制備方法簡單,成本低,為探索電催化活性氧殺菌防污裝置提供了可能。利用電催化產活性氧為海洋污損防治的開展提供一種新的思路。
 相關新聞
相關新聞